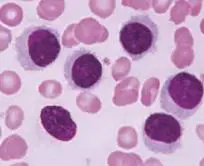
圖片

110年:(醫檢)血液(2)
Sézary Syndrome是一罕見的 T 細胞淋巴癌,但卻是最常見的皮膚 T 細胞淋巴癌,下列何種細胞最可能是 Sézary cell? 
A圖 

B圖 

C圖
D圖
詳細解析
本題觀念:
本題考點為皮膚 T 細胞淋巴癌 (Cutaneous T-Cell Lymphoma, CTCL) 中的 Sézary Syndrome 及其最具代表性的血液抹片細胞型態特徵。Sézary cell 的核心特徵是其細胞核呈現高度摺疊、類似腦回狀的結構 (Cerebriform nuclei)。
影像分析:
本題提供了四張不同的細胞型態圖片,我們逐一分析:
-
選項 A 圖片:
- 觀察:細胞核呈現極度不規則的摺疊與凹陷,核染色質緻密,核的表面像大腦皮質的溝回一樣 (grooved, convoluted),這就是所謂的腦回狀細胞核 (Cerebriform nuclei)。
- 判斷:這是 Sézary cell 的典型特徵。
-
選項 B 圖片:
- 觀察:這是一個巨大的多核細胞,擁有約四個圓形細胞核,核偏向一側,細胞質呈現嗜鹼性 (深藍色),且核旁有明顯的淺色區 (Golgi zone)。
- 判斷:這型態最像是一顆多核漿細胞 (Multinucleated Plasma Cell) 或發育異常的紅血球系細胞,並非 T 細胞淋巴癌的特徵。
-
選項 C 圖片 (最後一張): *
...(解析預覽)...

升級 VIP 解鎖圖文解析